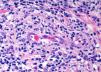
fig0015

Varón de 67 años que acude al Servicio de Urgencias por lesión tumoral no dolorosa en el labio inferior, de crecimiento lento y progresivo en los últimos dos meses. Además refería molestias a nivel latero-cervical derecho y sangrado ocasional de la lesión. En los antecedentes personales destacaba ser fumador de medio paquete/día y no reconocía conducta sexual de riesgo.
Exploración físicaEl examen físico puso de manifiesto la existencia de una lesión tumoral de 2cm de diámetro en la zona lateral derecha del labio inferior. La superficie se hallaba ulcerada y estaba cubierta por una costra serosa (fig. 1). A la palpación era indolora y el borde estaba indurado. Además se palpaban adenopatías latero-cervicales ipsilaterales indoloras. El paciente mantenía buen estado general, sin fiebre ni otra clínica acompañante.
HistopatologíaAnte la sospecha clínica de un proceso neoplásico se realizó una biopsia cutánea que mostró un intenso infiltrado inflamatorio afectando a todo el espesor de la dermis (fig. 2). Este infiltrado era polimorfo y destacaba la existencia de abundantes células plasmáticas, así como numerosas estructuras vasculares dilatadas asociadas a proliferación de células endoteliales (fig. 3). Ante estos resultados se realizó la tinción de Warthin-Starry, observándose estructuras espiriliformes de distribución predominantemente perivascular.
¿Cuál es su diagnóstico?
DiagnósticoChancro sifilítico en el labio.
Evolución y tratamientoTras el estudio anatomopatológico, altamente sugestivo de sífilis, se reinterrogó exhaustivamente al paciente que reconoció que en los últimos meses había mantenido múltiples contactos sexuales con múltiples parejas, y que conocía que una de ellas había sido diagnosticada de “una enfermedad venérea” en otro centro. Se solicitaron pruebas sifilíticas, mostrando el RPR un título de 1/32 y ELISA IgG+IgM positiva para sífilis.
Con la suma de los datos clínicos, dermatopatológicos y serológicos se procedió al diagnóstico de chancro sifilítico en el labio. Se administró tratamiento con penicilina G benzantina intramuscular (2.400.000 U) en dosis única. A las 4 semanas se observó resolución completa de la lesión, y buena respuesta serológica a los 6 meses, con descenso de los niveles de RPR a 1/4. El estudio de otras posibles infecciones de transmisión sexual resultó negativo.
ComentarioLa sífilis es una enfermedad de transmisión sexual causada por la espiroqueta Treponema pallidum. Su clínica varía dependiendo del estado evolutivo, siendo el chancro de localización genital la lesión clínica típica del período primario.
Sin embargo, el chancro se localiza en zonas extragenitales del 2 al 31% de los casos.
Puede aparecer en cualquier zona como los labios, la lengua, el paladar, la cara, la conjuntiva, el cuello, las mamas, el abdomen, la región interescapular, los brazos, las palmas de las manos y los dedos, entre otras. Entre el 40-70% de los chancros extragenitales se localizan en la cavidad oral, siendo los labios la zona más frecuentemente afectada1. Los chancros orales se manifiestan generalmente como lesiones erosionadas y ulceradas, indoloras, asociadas a linfoadenopatías regionales2. El diagnóstico diferencial de la sífilis primaria en la cavidad oral no sólo incluye infecciones herpéticas, sino además infecciones orales, carcinoma epidermoide, candidiasis, leucoplaquia, úlceras aftosas, tuberculosis cutánea, mononucleosis infecciosa, enfermedad por arañazo de gato y tularemia.
La falsa sensación de seguridad en cuanto a las relaciones de sexo oral en la población de hombres que mantienen sexo con hombres induce a la relajación en las medidas de protección3,4. De esta forma, el riesgo de aparición de chancros sifilíticos y otras ETS en esta localización es mayor. Además queremos resaltar la importancia de los antecedentes sexuales ante úlceras orales, ya que como ocurre en nuestro caso todavía está arraigado el pudor ante dichas prácticas.
Conflicto de interesesLos autores declaran no tener ningún conflicto de intereses.